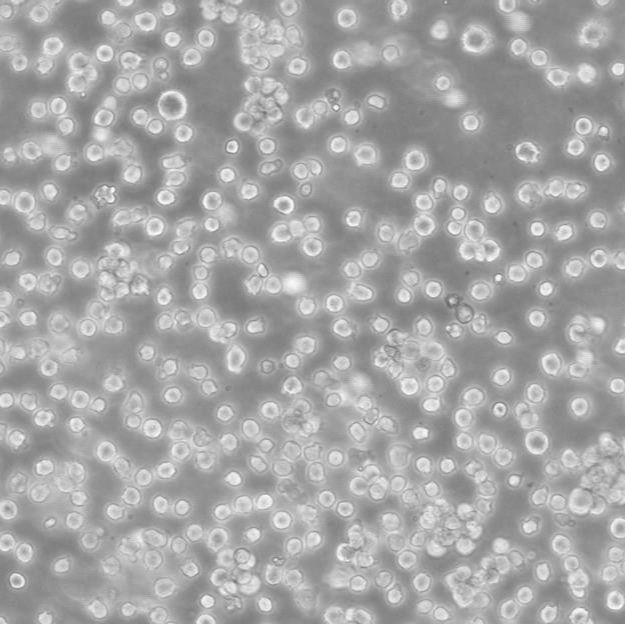
产品封面图

相关产品推荐更多 >
万千商家帮你免费找货
0 人在求购买到急需产品
- 详细信息
- 文献和实验
- 技术资料
- 品系:
详见细胞说明资料
- 细胞类型:
详见细胞说明资料
- 肿瘤类型:
详见细胞说明资料
- 供应商:
上海冠导生物工程有限公司
- 库存:
≥100瓶
- 生长状态:
详见细胞说明资料
- 年限:
详见细胞说明资料
- 运输方式:
常温运输【复苏细胞】或干冰运输【冻存细胞】
- 器官来源:
详见细胞说明资料
- 是否是肿瘤细胞:
详见细胞说明资料
- 细胞形态:
详见细胞说明资料
- 免疫类型:
详见细胞说明资料
- 物种来源:
详见细胞说明资料
- 相关疾病:
详见细胞说明资料
- 组织来源:
详见细胞说明资料
- 英文名:
NCI-H1792 Cells人肺腺癌细胞传代培养|STR图谱
- 规格:
1*10(6)Cellls/瓶
物种来源:NCI-H1792 Cells人肺腺癌细胞传代培养|STR图谱来源于人源、鼠源等其它物种来源
生长特性:NCI-H1792 Cells人肺腺癌细胞传代培养|STR图谱贴壁生长
形态特性:NCI-H1792 Cells人肺腺癌细胞传代培养|STR图谱上皮细胞样
实验人员需佩戴防爆面罩及双层无菌手套,尤其当发现冻存管液氮渗入时(管壁出现冰晶凝结为典型标志)。建议使用专门设计的液氮罐提取器,避免徒手接触-196℃的冻存管导致低温灼伤。解冻前准备37℃恒温水浴锅,水位需完全浸没冻存管液面线以上,并预热至温度稳定(±0.5℃波动范围)。
细胞培养是生物学和医学研究中不可或缺的技术手段,而温度作为细胞培养环境中的核心参数之一,直接影响细胞的生长、代谢和功能。维持恒定的适宜温度是确保细胞健康生长的关键因素。不同种类的细胞对温度的要求存在差异,而人体细胞的标准培养温度通常设定为36.5℃±0.5℃。这一温度范围模拟了人体内环境的稳态,能够地支持细胞的正常生理活动。
换液周期:NCI-H1792 Cells人肺腺癌细胞传代培养|STR图谱每周2-3次
产品包装:复苏发货:NCI-H1792 Cells人肺腺癌细胞传代培养|STR图谱T25培养瓶(一瓶)或冻存发货:1ml冻存管(两支)
背景信息:NCI-H1792 Cells人肺腺癌细胞传代培养|STR图谱详见相关文献介绍
细胞消化注意事项(二):细胞状态:在消化前,应确保细胞处于适宜的状态,如生长密度、形态和活力等。后续操作:消化后的细胞应立即进行后续操作,如传代、分离或计数等,以避免细胞在体外过长时间暴露而导致损伤或死亡。细胞消化是细胞培养中的一个关键步骤,需要严格遵循操作规程和注意事项,以确保细胞的良好分离和后续实验的顺利进行。
当T25瓶复苏细胞收到货时,请观察好细胞状态后,将T25细胞瓶壁进行75%酒精消毒,将T25瓶置于37度培养箱放置2-4h,以便稳定细胞状态,当细胞密度达80%-90%,即可进行首次传代培养;干冰运输的细胞冻存管收到货后,需立即转入液氮保存或直接进行复苏(第三天换液并检查复苏细胞密度,以便进行下一步)。 能够在实验室条件下进行大量培养和繁殖。这种细胞系在分子生物学和生物技术研究中十分常用。
传代比例:1:2-1:4(NCI-H1792 Cells人肺腺癌细胞传代培养|STR图谱首次传代建议1:2)
来源说明:NCI-H1792 Cells人肺腺癌细胞传代培养|STR图谱主要来源ATCC、ECACC、DSMZ、RCB等细胞库
在细胞培养的精密舞台上,细胞消化犹如一位技艺精湛的拆解师,它挥舞着胰蛋白酶的魔法剪刀,精准剪断细胞间紧密相连的""分子纽带""。这个关键步骤如同为细胞群举行温柔的告别仪式,当进行传代培养、细胞分离或精确计数时,那些原本紧密贴附在培养器皿底部的细胞,便在酶的作用下优雅地褪去牵绊,化作漫天繁星般的单细胞悬液,为后续实验铺就璀璨的通途。
二氧化碳培养箱是细胞培养的核心设备,其内部环境容易滋生细菌和真菌。定期消毒培养箱是预防污染的重要措施。具体操作包括:使用75%酒精擦拭培养箱内壁和隔板,去除可能的污染物。使用可移动的紫外灯对培养箱内部照射至少30分钟,以杀灭残留的微生物。培养箱的水槽用于维持湿度,但长期使用容易滋生微生物。建议使用高压灭菌的超纯水,或加入铜离子溶液(如300ml饱和硫酸铜溶液与3 L灭菌超纯水混合),利用铜离子的抑菌作用减少污染风险。
NCI-SNU-520 Cells;背景说明:详见相关文献介绍;传代方法:1:2-1:3传代;每周换液2-3次。;生长特性:贴壁或悬浮,详见产品说明书部分;形态特性:详见产品说明书;相关产品有:SUM-159细胞、H-2029细胞、NCIH1770细胞
SW 626 Cells;背景说明:卵巢癌;传代方法:1:2-1:3传代;每周换液2-3次。;生长特性:贴壁;形态特性:详见产品说明书;相关产品有:LC-1/sq细胞、HK-2 [Human kidney]细胞、159 PT细胞
T47D:A Cells;背景说明:浸润性导管癌;胸腔积液转移;女性;传代方法:1:2-1:3传代;每周换液2-3次。;生长特性:贴壁;形态特性:详见产品说明书;相关产品有:PL-45细胞、FLC7细胞、OACP4 C细胞
LC1/Sq Cells;背景说明:详见相关文献介绍;传代方法:1:2-1:3传代;每周换液2-3次。;生长特性:贴壁或悬浮,详见产品说明书部分;形态特性:详见产品说明书;相关产品有:Hs 822.T细胞、Be-Wo细胞、HCC-1806细胞
BE2_C Cells;背景说明:神经母细胞瘤;骨髓转移;男性;传代方法:1:2-1:3传代;每周换液2-3次。;生长特性:贴壁;形态特性:详见产品说明书;相关产品有:SJRH30细胞、HN4细胞、AE1201细胞
5637 Cells;背景说明:该细胞源于一位68岁的患有膀胱癌的白人男性患者。据报道,该细胞能产生SCF、IL-1、IL-3、IL-6、G-CSF、GM-CSF等。;传代方法:1:4-1:8传代;每周换液2-3次。;生长特性:贴壁生长;形态特性:上皮样;相关产品有:2T细胞、H292细胞、SUP T1细胞
HEL9217 Cells;背景说明:详见相关文献介绍;传代方法:每周2-3次。;生长特性:悬浮生长;形态特性:成淋巴细胞;相关产品有:Kato-III细胞、H1836细胞、TE 85.T细胞
LX-2 Cells人肝星状细胞库专业复苏|带STR图谱
SNU-719 Cells人胃癌细胞库专业复苏|带STR图谱
3D4/21 Cells猪肺泡巨噬细胞库专业复苏|带STR图谱
A-253 Cells人颌下腺表皮癌细胞库专业复苏|带STR图谱
NCI-H1792 Cells人肺腺癌细胞传代培养|STR图谱
HeLa S3 Cells人宫颈癌细胞库专业复苏|带STR图谱
HEY A8 Cells人卵巢癌细胞库专业复苏|带STR图谱
B16-F10-Luc Cells小鼠黑色素瘤细胞库专业复苏|带STR图谱
HuT 78 Cells人T淋巴细胞白血病细胞库专业复苏|带STR图谱
DMS-153 Cells人小细胞肺癌细胞库专业复苏|带STR图谱
NP69 Cells;背景说明:鼻咽;上皮细胞;SV40转化;传代方法:1:2-1:3传代;每周换液2-3次。;生长特性:贴壁;形态特性:详见产品说明书;相关产品有:H-2023细胞、LM(TK-)细胞、NCI-H1573细胞
5G6 Cells(提供STR鉴定图谱)
K562/ADR Cells;背景说明:详见相关文献介绍;传代方法:1:2-1:3传代;每周换液2-3次。;生长特性:贴壁或悬浮,详见产品说明书部分;形态特性:详见产品说明书;相关产品有:LCMS细胞、PG-4细胞、HSC-I细胞
SNK1 Cells;背景说明:NK/T细胞淋巴瘤;女性;传代方法:1:2-1:3传代;每周换液2-3次。;生长特性:悬浮;形态特性:详见产品说明书;相关产品有:H1882细胞、NCI-H847细胞、Human Hepatocyte Line 5细胞
OCI-LY-1 Cells;背景说明:弥漫大B淋巴瘤;男性;传代方法:1:2-1:3传代;每周换液2-3次。;生长特性:悬浮;形态特性:详见产品说明书;相关产品有:Hs 445细胞、L6细胞、SMMC7721细胞
H1869 Cells;背景说明:详见相关文献介绍;传代方法:1:3-1:4传代;每周换液2次。;生长特性:贴壁生长;形态特性:上皮细胞;相关产品有:PA12细胞、SW900细胞、H283细胞
BEAS-2B Cells人支气管上皮细胞库专业复苏|带STR图谱
HuH-6 Cells人肝母细胞瘤细胞库专业复苏|带STR图谱
NCI-H1792 Cells人肺腺癌细胞传代培养|STR图谱
SW948 Cells人结肠腺癌细胞库专业复苏|带STR图谱
NCI-H2009 Cells人肺腺癌细胞库专业复苏|带STR图谱
Y3-Ag 1.2.3 Cells大鼠骨髓瘤细胞库专业复苏|带STR图谱
JVM-2 Cells人套细胞淋巴瘤细胞库专业复苏|带STR图谱
PT67 Cells小鼠逆转录病毒包装细胞库专业复苏|带STR图谱
MDA-MB-231+luc Cells人乳腺癌细胞库专业复苏|带STR图谱
ChaGo-K-1 Cells人肺癌细胞库专业复苏|带STR图谱
CNE1 Cells;背景说明:详见相关文献介绍;传代方法:1:2-1:3传代;每周换液2-3次。;生长特性:贴壁或悬浮,详见产品说明书部分;形态特性:详见产品说明书;相关产品有:OE33细胞、KMS-11细胞、HEK-293细胞
MNNGHOS Cells;背景说明:骨肉瘤;女性;传代方法:1:2-1:3传代;每周换液2-3次。;生长特性:贴壁;形态特性:详见产品说明书;相关产品有:BIC1细胞、V 79细胞、H28细胞
MNNGHOS Cells;背景说明:骨肉瘤;女性;传代方法:1:2-1:3传代;每周换液2-3次。;生长特性:贴壁;形态特性:详见产品说明书;相关产品有:BIC1细胞、V 79细胞、H28细胞
RT 112 Cells;背景说明:详见相关文献介绍;传代方法:1:2-1:3传代;每周换液2-3次。;生长特性:贴壁或悬浮,详见产品说明书部分;形态特性:详见产品说明书;相关产品有:PLC/PRF5细胞、H-2291细胞、KYSE0520细胞
GM24646 Cells(提供STR鉴定图谱)
HAP1 NOS2 (-) 2 Cells(提供STR鉴定图谱)
MM.1R Cells人多发性骨髓瘤细胞库专业复苏|带STR图谱
MDA-MB-231+luc Cells人乳腺癌细胞库专业复苏|带STR图谱
MKN-74-GFP Cells人胃癌细胞库专业复苏|带STR图谱
HuT 102 Cells人T淋巴瘤细胞库专业复苏|带STR图谱
MDA-MB-468 Cells人乳腺癌细胞库专业复苏|带STR图谱
RAW264.7-RFP Cells小鼠单核巨噬细胞白血病细胞库专业复苏|带STR图谱
SNU-182 Cells人肝癌细胞库专业复苏|带STR图谱
Panc 05.04 Cells人胰腺癌细胞库专业复苏|带STR图谱
B16-F10/OVA Cells小鼠黑色素瘤细胞库专业复苏|带STR图谱
UCD-MLA-144 Cells;背景说明:详见相关文献介绍;传代方法:1:2-1:3传代;每周换液2-3次。;生长特性:贴壁或悬浮,详见产品说明书部分;形态特性:详见产品说明书;相关产品有:SW-900细胞、L132细胞、SK MEL 5细胞
H-3255 Cells;背景说明:详见相关文献介绍;传代方法:1:2传代;生长特性:贴壁生长 ;形态特性:详见产品说明书;相关产品有:HT 1080细胞、RL95细胞、B16-F10--RED细胞
RINm5F Cells;背景说明:胰岛β细胞瘤;雄性;NEDH;传代方法:1:2-1:3传代;每周换液2-3次。;生长特性:贴壁;形态特性:详见产品说明书;相关产品有:AMO1细胞、U138MG细胞、SKHEP-1细胞
HCT-15 Cells;背景说明:详见相关文献介绍;传代方法:1:2-1:3传代;每周换液2-3次。;生长特性:贴壁或悬浮,详见产品说明书部分;形态特性:详见产品说明书;相关产品有:HEK293E细胞、J-82细胞、U373 MG细胞
MFM223 Cells;背景说明:详见相关文献介绍;传代方法:1:2-1:3传代;每周换液2-3次。;生长特性:贴壁或悬浮,详见产品说明书部分;形态特性:详见产品说明书;相关产品有:TMD8细胞、Hepatoma 22细胞、P3J-HR-1细胞
UMNSAH/DF#1 Cells;背景说明:详见相关文献介绍;传代方法:1:2传代;生长特性:贴壁生长;形态特性:成纤维母细胞样;相关产品有:SUM 149细胞、HELF细胞、IEC-18细胞
RS4;11 Cells人急性淋巴白血病细胞库专业复苏|带STR图谱
OVCAR-3-GFP Cells人卵巢癌腺癌细胞库专业复苏|带STR图谱
COLO 320 Cells人结直肠腺癌细胞库专业复苏|带STR图谱
HCCLM3-luc Cells人高转移肝癌细胞库专业复苏|带STR图谱
NCI-H1792 Cells人肺腺癌细胞传代培养|STR图谱
Akata-GFP Cells人淋巴细胞库专业复苏|带STR图谱
H9c2 Cells;背景说明:详见相关文献介绍;传代方法:1:2传代;生长特性:贴壁生长 ;形态特性:详见产品说明书;相关产品有:DU_145细胞、HOS(TE85)细胞、FOX-NY细胞
RL-952 Cells;背景说明:这些细胞有α角蛋白,定义明确的连接复合体,张力丝和表面微绒毛。;传代方法:1:2传代;生长特性:贴壁生长;形态特性:上皮样;相关产品有:B16细胞、BEND细胞、TE3A细胞
Hs 124.Tg Cells(提供STR鉴定图谱)
KM-102 Cells(提供STR鉴定图谱)
B16-F1 Cells小鼠黑色素瘤细胞库专业复苏|带STR图谱
NOZ Cells人胆囊癌细胞库专业复苏|带STR图谱
EBTr Cells牛胚气管细胞库专业复苏|带STR图谱
HET-1A Cells人食管上皮细胞库专业复苏|带STR图谱
Mink Lung Cells;背景说明:详见相关文献介绍;传代方法:1:2-1:3传代;每周换液2-3次。;生长特性:贴壁或悬浮,详见产品说明书部分;形态特性:详见产品说明书;相关产品有:NCI-H1915细胞、HCC-44细胞、LNCaP clone FGC细胞
PaTu8988s Cells;背景说明:胰腺癌;女性;传代方法:1:2-1:3传代;每周换液2-3次。;生长特性:贴壁;形态特性:详见产品说明书;相关产品有:Hs863T细胞、HCEC-B4G12细胞、HPBALL细胞
TE4 Cells;背景说明:详见相关文献介绍;传代方法:1:2-1:3传代;每周换液2-3次。;生长特性:贴壁或悬浮,详见产品说明书部分;形态特性:详见产品说明书;相关产品有:RKO_AS45细胞、SNB-19细胞、BrCL18细胞
HG02942 Cells(提供STR鉴定图谱)
CCD1112Sk Cells;背景说明:详见相关文献介绍;传代方法:1:2-1:3传代;每周换液2-3次。;生长特性:贴壁或悬浮,详见产品说明书部分;形态特性:详见产品说明书;相关产品有:NB1RGB细胞、BL6细胞、MV-4:11细胞
RKO Cells;背景说明:RKO是一个低分化的结肠癌细胞系。RKO细胞含有野生型P53,但缺乏人甲状腺受体核受体(h-TRbeta1)。RKO细胞的P53蛋白的水平高于RKO-E6细胞。RKO细胞系是RKO-E6和RKO-AS45-1的亲本细胞系。该细胞系在裸鼠中成瘤,且在软琼脂中形成集落。;传代方法:消化3-5分钟。1:2。3天内可长满。;生长特性:贴壁生长;形态特性:上皮样;相关产品有:WM451Lu细胞、SKML-28细胞、HSC(Human Schwann)细胞
A375 Cells;背景说明:A375源自一位54岁女性,是Giard DJ等人建立的一系列细胞株中的一株。该细胞可在免疫抑制小鼠上成瘤,在琼脂上形成克隆。;传代方法:1:2-1:3传代;每周换液2-3次。;生长特性:贴壁;形态特性:上皮细胞样;相关产品有:LOUNH91细胞、NTC-200细胞、Lewis Lung Cancer细胞
CT 26 Cells;背景说明:详见相关文献介绍;传代方法:1:2-1:3传代;每周换液2-3次。;生长特性:贴壁或悬浮,详见产品说明书部分;形态特性:详见产品说明书;相关产品有:NCI/ADR-RES细胞、CMT 64细胞、GM-346细胞
HEK293-A Cells人胚肾细胞库专业复苏|带STR图谱
HCC-LM3+luc Cells人高转移肝癌细胞库专业复苏|带STR图谱
PANC02+luc Cells小鼠胰腺癌细胞库专业复苏|带STR图谱
NCI-H1792 Cells人肺腺癌细胞传代培养|STR图谱
U14 Cells小鼠子宫颈癌细胞库专业复苏|带STR图谱
293T-GFP Cells人胚肾细胞库专业复苏|带STR图谱
NCI-H508[H508] Cells人结肠直肠腺癌细胞库专业复苏|带STR图谱
ML-DmD16-c7 Cells(提供STR鉴定图谱)
NRK-EGFP-H2B Cells(提供STR鉴定图谱)
RECC-KU3 Cells(提供STR鉴定图谱)
U3073MG Cells(提供STR鉴定图谱)
UMGi042-A Cells(提供STR鉴定图谱)
" "PubMed=12068308; DOI=10.1038/nature00766
Davies H.R., Bignell G.R., Cox C., Stephens P.J., Edkins S., Clegg S., Teague J.W., Woffendin H., Garnett M.J., Bottomley W., Davis N., Dicks E., Ewing R., Floyd Y., Gray K., Hall S., Hawes R., Hughes J., Kosmidou V., Menzies A., Mould C., Parker A., Stevens C., Watt S., Hooper S., Wilson R., Jayatilake H., Gusterson B.A., Cooper C.S., Shipley J.M., Hargrave D., Pritchard-Jones K., Maitland N.J., Chenevix-Trench G., Riggins G.J., Bigner D.D., Palmieri G., Cossu A., Flanagan A.M., Nicholson A., Ho J.W.C., Leung S.Y., Yuen S.T., Weber B.L., Seigler H.F., Darrow T.L., Paterson H.F., Marais R., Marshall C.J., Wooster R., Stratton M.R., Futreal P.A.
Mutations of the BRAF gene in human cancer.
Nature 417:949-954(2002)
PubMed=18083107; DOI=10.1016/j.cell.2007.11.025
Rikova K., Guo A.-L., Zeng Q.-F., Possemato A., Yu J., Haack H., Nardone J., Lee K., Reeves C., Li Y., Hu Y.-R., Tan Z.-P., Stokes M.P., Sullivan L., Mitchell J., Wetzel R., MacNeill J., Ren J.-M., Yuan J., Bakalarski C.E., Villen J., Kornhauser J.M., Smith B., Li D.-Q., Zhou X.-M., Gygi S.P., Gu T.-L., Polakiewicz R.D., Rush J., Comb M.J.
Global survey of phosphotyrosine signaling identifies oncogenic kinases in lung cancer.
Cell 131:1190-1203(2007)
PubMed=20164919; DOI=10.1038/nature08768; PMCID=PMC3145113
Bignell G.R., Greenman C.D., Davies H.R., Butler A.P., Edkins S., Andrews J.M., Buck G., Chen L., Beare D., Latimer C., Widaa S., Hinton J., Fahey C., Fu B.-Y., Swamy S., Dalgliesh G.L., Teh B.T., Deloukas P., Yang F.-T., Campbell P.J., Futreal P.A., Stratton M.R.
Signatures of mutation and selection in the cancer genome.
Nature 463:893-898(2010)
PubMed=20215515; DOI=10.1158/0008-5472.CAN-09-3458; PMCID=PMC2881662
Rothenberg S.M., Mohapatra G., Rivera M.N., Winokur D., Greninger P., Nitta M., Sadow P.M., Sooriyakumar G., Brannigan B.W., Ulman M.J., Perera R.M., Wang R., Tam A., Ma X.-J., Erlander M., Sgroi D.C., Rocco J.W., Lingen M.W., Cohen E.E.W., Louis D.N., Settleman J., Haber D.A.
A genome-wide screen for microdeletions reveals disruption of polarity complex genes in diverse human cancers.
Cancer Res. 70:2158-2164(2010)
PubMed=22460905; DOI=10.1038/nature11003; PMCID=PMC3320027
Barretina J.G., Caponigro G., Stransky N., Venkatesan K., Margolin A.A., Kim S., Wilson C.J., Lehar J., Kryukov G.V., Sonkin D., Reddy A., Liu M., Murray L., Berger M.F., Monahan J.E., Morais P., Meltzer J., Korejwa A., Jane-Valbuena J., Mapa F.A., Thibault J., Bric-Furlong E., Raman P., Shipway A., Engels I.H., Cheng J., Yu G.-Y.K., Yu J.-J., Aspesi P. Jr., de Silva M., Jagtap K., Jones M.D., Wang L., Hatton C., Palescandolo E., Gupta S., Mahan S., Sougnez C., Onofrio R.C., Liefeld T., MacConaill L.E., Winckler W., Reich M., Li N.-X., Mesirov J.P., Gabriel S.B., Getz G., Ardlie K., Chan V., Myer V.E., Weber B.L., Porter J., Warmuth M., Finan P., Harris J.L., Meyerson M.L., Golub T.R., Morrissey M.P., Sellers W.R., Schlegel R., Garraway L.A.
The Cancer Cell Line Encyclopedia enables predictive modelling of anticancer drug sensitivity.
Nature 483:603-607(2012)
PubMed=22961666; DOI=10.1158/2159-8290.CD-12-0112; PMCID=PMC3567922
Byers L.A., Wang J., Nilsson M.B., Fujimoto J., Saintigny P., Yordy J.S., Giri U., Peyton M., Fan Y.-H., Diao L.-X., Masrorpour F., Shen L., Liu W.-B., Duchemann B., Tumula P., Bhardwaj V., Welsh J., Weber S., Glisson B.S., Kalhor N., Wistuba I.I., Girard L., Lippman S.M., Mills G.B., Coombes K.R., Weinstein J.N., Minna J.D., Heymach J.V.
Proteomic profiling identifies dysregulated pathways in small cell lung cancer and novel therapeutic targets including PARP1.
Cancer Discov. 2:798-811(2012)
PubMed=24135919; DOI=10.1038/ncomms3617; PMCID=PMC4107456
Balbin O.A., Prensner J.R., Sahu A., Yocum A., Shankar S., Malik R., Fermin D., Dhanasekaran S.M., Chandler B., Thomas D., Beer D.G., Cao X.-H., Nesvizhskii A.I., Chinnaiyan A.M.
Reconstructing targetable pathways in lung cancer by integrating diverse omics data.
Nat. Commun. 4:2617.1-2617.13(2013)
PubMed=25984343; DOI=10.1038/sdata.2014.35; PMCID=PMC4432652
Cowley G.S., Weir B.A., Vazquez F., Tamayo P., Scott J.A., Rusin S., East-Seletsky A., Ali L.D., Gerath W.F.J., Pantel S.E., Lizotte P.H., Jiang G.-Z., Hsiao J., Tsherniak A., Dwinell E., Aoyama S., Okamoto M., Harrington W., Gelfand E.T., Green T.M., Tomko M.J., Gopal S., Wong T.C., Li H.-B., Howell S., Stransky N., Liefeld T., Jang D., Bistline J., Meyers B.H., Armstrong S.A., Anderson K.C., Stegmaier K., Reich M., Pellman D., Boehm J.S., Mesirov J.P., Golub T.R., Root D.E., Hahn W.C.
Parallel genome-scale loss of function screens in 216 cancer cell lines for the identification of context-specific genetic dependencies.
Sci. Data 1:140035-140035(2014)
PubMed=25485619; DOI=10.1038/nbt.3080
Klijn C., Durinck S., Stawiski E.W., Haverty P.M., Jiang Z.-S., Liu H.-B., Degenhardt J., Mayba O., Gnad F., Liu J.-F., Pau G., Reeder J., Cao Y., Mukhyala K., Selvaraj S.K., Yu M.-M., Zynda G.J., Brauer M.J., Wu T.D., Gentleman R.C., Manning G., Yauch R.L., Bourgon R., Stokoe D., Modrusan Z., Neve R.M., de Sauvage F.J., Settleman J., Seshagiri S., Zhang Z.-M.
A comprehensive transcriptional portrait of human cancer cell lines.
Nat. Biotechnol. 33:306-312(2015)
PubMed=25877200; DOI=10.1038/nature14397
Yu M., Selvaraj S.K., Liang-Chu M.M.Y., Aghajani S., Busse M., Yuan J., Lee G., Peale F.V., Klijn C., Bourgon R., Kaminker J.S., Neve R.M.
A resource for cell line authentication, annotation and quality control.
Nature 520:307-311(2015)
PubMed=26589293; DOI=10.1186/s13073-015-0240-5; PMCID=PMC4653878
Scholtalbers J., Boegel S., Bukur T., Byl M., Goerges S., Sorn P., Loewer M., Sahin U., Castle J.C.
TCLP: an online cancer cell line catalogue integrating HLA type, predicted neo-epitopes, virus and gene expression.
Genome Med. 7:118.1-118.7(2015)
PubMed=27397505; DOI=10.1016/j.cell.2016.06.017; PMCID=PMC4967469
Iorio F., Knijnenburg T.A., Vis D.J., Bignell G.R., Menden M.P., Schubert M., Aben N., Goncalves E., Barthorpe S., Lightfoot H., Cokelaer T., Greninger P., van Dyk E., Chang H., de Silva H., Heyn H., Deng X.-M., Egan R.K., Liu Q.-S., Miroo T., Mitropoulos X., Richardson L., Wang J.-H., Zhang T.-H., Moran S., Sayols S., Soleimani M., Tamborero D., Lopez-Bigas N., Ross-Macdonald P., Esteller M., Gray N.S., Haber D.A., Stratton M.R., Benes C.H., Wessels L.F.A., Saez-Rodriguez J., McDermott U., Garnett M.J.
A landscape of pharmacogenomic interactions in cancer.
Cell 166:740-754(2016)
PubMed=28196595; DOI=10.1016/j.ccell.2017.01.005; PMCID=PMC5501076
Li J., Zhao W., Akbani R., Liu W.-B., Ju Z.-L., Ling S.-Y., Vellano C.P., Roebuck P., Yu Q.-H., Eterovic A.K., Byers L.A., Davies M.A., Deng W.-L., Gopal Y.N.V., Chen G., von Euw E.M., Slamon D.J., Conklin D., Heymach J.V., Gazdar A.F., Minna J.D., Myers J.N., Lu Y.-L., Mills G.B., Liang H.
Characterization of human cancer cell lines by reverse-phase protein arrays.
Cancer Cell 31:225-239(2017)
PubMed=29444439; DOI=10.1016/j.celrep.2018.01.051; PMCID=PMC6343826
Yuan T.L., Amzallag A., Bagni R., Yi M., Afghani S., Burgan W., Fer N., Strathern L.A., Powell K., Smith B., Waters A.M., Drubin D.A., Thomson T., Liao R., Greninger P., Stein G.T., Murchie E., Cortez E., Egan R.K., Procter L., Bess M., Cheng K.T., Lee C.-S., Lee L.C., Fellmann C., Stephens R., Luo J., Lowe S.W., Benes C.H., McCormick F.
Differential effector engagement by oncogenic KRAS.
Cell Rep. 22:1889-1902(2018)
PubMed=29681454; DOI=10.1016/j.cell.2018.03.028; PMCID=PMC5935540
McMillan E.A., Ryu M.-J., Diep C.H., Mendiratta S., Clemenceau J.R., Vaden R.M., Kim J.-H., Motoyaji T., Covington K.R., Peyton M., Huffman K., Wu X.-F., Girard L., Sung Y., Chen P.-H., Mallipeddi P.L., Lee J.Y., Hanson J., Voruganti S., Yu Y., Park S., Sudderth J., DeSevo C., Muzny D.M., Doddapaneni H., Gazdar A.F., Gibbs R.A., Hwang T.H., Heymach J.V., Wistuba I.I., Coombes K.R., Williams N.S., Wheeler D.A., MacMillan J.B., DeBerardinis R.J., Roth M.G., Posner B.A., Minna J.D., Kim H.S., White M.A.
Chemistry-first approach for nomination of personalized treatment in lung cancer.
Cell 173:864-878.e29(2018)
PubMed=30894373; DOI=10.1158/0008-5472.CAN-18-2747; PMCID=PMC6445675
Dutil J., Chen Z.-H., Monteiro A.N.A., Teer J.K., Eschrich S.A.
An interactive resource to probe genetic diversity and estimated ancestry in cancer cell lines.
Cancer Res. 79:1263-1273(2019)
PubMed=31068700; DOI=10.1038/s41586-019-1186-3; PMCID=PMC6697103
Ghandi M., Huang F.W., Jane-Valbuena J., Kryukov G.V., Lo C.C., McDonald E.R. 3rd, Barretina J.G., Gelfand E.T., Bielski C.M., Li H.-X., Hu K., Andreev-Drakhlin A.Y., Kim J., Hess J.M., Haas B.J., Aguet F., Weir B.A., Rothberg M.V., Paolella B.R., Lawrence M.S., Akbani R., Lu Y.-L., Tiv H.L., Gokhale P.C., de Weck A., Mansour A.A., Oh C., Shih J., Hadi K., Rosen Y., Bistline J., Venkatesan K., Reddy A., Sonkin D., Liu M., Lehar J., Korn J.M., Porter D.A., Jones M.D., Golji J., Caponigro G., Taylor J.E., Dunning C.M., Creech A.L., Warren A.C., McFarland J.M., Zamanighomi M., Kauffmann A., Stransky N., Imielinski M., Maruvka Y.E., Cherniack A.D., Tsherniak A., Vazquez F., Jaffe J.D., Lane A.A., Weinstock D.M., Johannessen C.M., Morrissey M.P., Stegmeier F., Schlegel R., Hahn W.C., Getz G., Mills G.B., Boehm J.S., Golub T.R., Garraway L.A., Sellers W.R.
Next-generation characterization of the Cancer Cell Line Encyclopedia.
Nature 569:503-508(2019)
PubMed=31467290; DOI=10.1038/s41597-019-0166-7; PMCID=PMC6715692
Schoenherr R.M., Huang D.-Q., Voytovich U.J., Ivey R.G., Kennedy J.J., Saul R.G., Colantonio S., Roberts R.R., Knotts J.G., Kaczmarczyk J.A., Perry C., Hewitt S.M., Bocik W., Whiteley G.R., Hiltke T., Boja E.S., Rodriguez H., Whiteaker J.R., Paulovich A.G.
A dataset describing a suite of novel antibody reagents for the RAS signaling network.
Sci. Data 6:160-160(2019)"
风险提示:丁香通仅作为第三方平台,为商家信息发布提供平台空间。用户咨询产品时请注意保护个人信息及财产安全,合理判断,谨慎选购商品,商家和用户对交易行为负责。对于医疗器械类产品,请先查证核实企业经营资质和医疗器械产品注册证情况。
 文献和实验
文献和实验Davies H.R., Bignell G.R., Cox C., Stephens P.J., Edkins S., Clegg S., Teague J.W., Woffendin H., Garnett M.J., Bottomley W., Davis N., Dicks E., Ewing R., Floyd Y., Gray K., Hall S., Hawes R., Hughes J., Kosmidou V., Menzies A., Mould C., Parker A., Stevens C., Watt S., Hooper S., Wilson R., Jayatilake H., Gusterson B.A., Cooper C.S., Shipley J.M., Hargrave D., Pritchard-Jones K., Maitland N.J., Chenevix-Trench G., Riggins G.J., Bigner D.D., Palmieri G., Cossu A., Flanagan A.M., Nicholson A., Ho J.W.C., Leung S.Y., Yuen S.T., Weber B.L., Seigler H.F., Darrow T.L., Paterson H.F., Marais R., Marshall C.J., Wooster R., Stratton M.R., Futreal P.A.
Mutations of the BRAF gene in human cancer.
Nature 417:949-954(2002)
PubMed=18083107; DOI=10.1016/j.cell.2007.11.025
Rikova K., Guo A.-L., Zeng Q.-F., Possemato A., Yu J., Haack H., Nardone J., Lee K., Reeves C., Li Y., Hu Y.-R., Tan Z.-P., Stokes M.P., Sullivan L., Mitchell J., Wetzel R., MacNeill J., Ren J.-M., Yuan J., Bakalarski C.E., Villen J., Kornhauser J.M., Smith B., Li D.-Q., Zhou X.-M., Gygi S.P., Gu T.-L., Polakiewicz R.D., Rush J., Comb M.J.
Global survey of phosphotyrosine signaling identifies oncogenic kinases in lung cancer.
Cell 131:1190-1203(2007)
PubMed=20164919; DOI=10.1038/nature08768; PMCID=PMC3145113
Bignell G.R., Greenman C.D., Davies H.R., Butler A.P., Edkins S., Andrews J.M., Buck G., Chen L., Beare D., Latimer C., Widaa S., Hinton J., Fahey C., Fu B.-Y., Swamy S., Dalgliesh G.L., Teh B.T., Deloukas P., Yang F.-T., Campbell P.J., Futreal P.A., Stratton M.R.
Signatures of mutation and selection in the cancer genome.
Nature 463:893-898(2010)
PubMed=20215515; DOI=10.1158/0008-5472.CAN-09-3458; PMCID=PMC2881662
Rothenberg S.M., Mohapatra G., Rivera M.N., Winokur D., Greninger P., Nitta M., Sadow P.M., Sooriyakumar G., Brannigan B.W., Ulman M.J., Perera R.M., Wang R., Tam A., Ma X.-J., Erlander M., Sgroi D.C., Rocco J.W., Lingen M.W., Cohen E.E.W., Louis D.N., Settleman J., Haber D.A.
A genome-wide screen for microdeletions reveals disruption of polarity complex genes in diverse human cancers.
Cancer Res. 70:2158-2164(2010)
PubMed=22460905; DOI=10.1038/nature11003; PMCID=PMC3320027
Barretina J.G., Caponigro G., Stransky N., Venkatesan K., Margolin A.A., Kim S., Wilson C.J., Lehar J., Kryukov G.V., Sonkin D., Reddy A., Liu M., Murray L., Berger M.F., Monahan J.E., Morais P., Meltzer J., Korejwa A., Jane-Valbuena J., Mapa F.A., Thibault J., Bric-Furlong E., Raman P., Shipway A., Engels I.H., Cheng J., Yu G.-Y.K., Yu J.-J., Aspesi P. Jr., de Silva M., Jagtap K., Jones M.D., Wang L., Hatton C., Palescandolo E., Gupta S., Mahan S., Sougnez C., Onofrio R.C., Liefeld T., MacConaill L.E., Winckler W., Reich M., Li N.-X., Mesirov J.P., Gabriel S.B., Getz G., Ardlie K., Chan V., Myer V.E., Weber B.L., Porter J., Warmuth M., Finan P., Harris J.L., Meyerson M.L., Golub T.R., Morrissey M.P., Sellers W.R., Schlegel R., Garraway L.A.
The Cancer Cell Line Encyclopedia enables predictive modelling of anticancer drug sensitivity.
Nature 483:603-607(2012)
PubMed=22961666; DOI=10.1158/2159-8290.CD-12-0112; PMCID=PMC3567922
Byers L.A., Wang J., Nilsson M.B., Fujimoto J., Saintigny P., Yordy J.S., Giri U., Peyton M., Fan Y.-H., Diao L.-X., Masrorpour F., Shen L., Liu W.-B., Duchemann B., Tumula P., Bhardwaj V., Welsh J., Weber S., Glisson B.S., Kalhor N., Wistuba I.I., Girard L., Lippman S.M., Mills G.B., Coombes K.R., Weinstein J.N., Minna J.D., Heymach J.V.
Proteomic profiling identifies dysregulated pathways in small cell lung cancer and novel therapeutic targets including PARP1.
Cancer Discov. 2:798-811(2012)
PubMed=24135919; DOI=10.1038/ncomms3617; PMCID=PMC4107456
Balbin O.A., Prensner J.R., Sahu A., Yocum A., Shankar S., Malik R., Fermin D., Dhanasekaran S.M., Chandler B., Thomas D., Beer D.G., Cao X.-H., Nesvizhskii A.I., Chinnaiyan A.M.
Reconstructing targetable pathways in lung cancer by integrating diverse omics data.
Nat. Commun. 4:2617.1-2617.13(2013)
PubMed=25984343; DOI=10.1038/sdata.2014.35; PMCID=PMC4432652
Cowley G.S., Weir B.A., Vazquez F., Tamayo P., Scott J.A., Rusin S., East-Seletsky A., Ali L.D., Gerath W.F.J., Pantel S.E., Lizotte P.H., Jiang G.-Z., Hsiao J., Tsherniak A., Dwinell E., Aoyama S., Okamoto M., Harrington W., Gelfand E.T., Green T.M., Tomko M.J., Gopal S., Wong T.C., Li H.-B., Howell S., Stransky N., Liefeld T., Jang D., Bistline J., Meyers B.H., Armstrong S.A., Anderson K.C., Stegmaier K., Reich M., Pellman D., Boehm J.S., Mesirov J.P., Golub T.R., Root D.E., Hahn W.C.
Parallel genome-scale loss of function screens in 216 cancer cell lines for the identification of context-specific genetic dependencies.
Sci. Data 1:140035-140035(2014)
PubMed=25485619; DOI=10.1038/nbt.3080
Klijn C., Durinck S., Stawiski E.W., Haverty P.M., Jiang Z.-S., Liu H.-B., Degenhardt J., Mayba O., Gnad F., Liu J.-F., Pau G., Reeder J., Cao Y., Mukhyala K., Selvaraj S.K., Yu M.-M., Zynda G.J., Brauer M.J., Wu T.D., Gentleman R.C., Manning G., Yauch R.L., Bourgon R., Stokoe D., Modrusan Z., Neve R.M., de Sauvage F.J., Settleman J., Seshagiri S., Zhang Z.-M.
A comprehensive transcriptional portrait of human cancer cell lines.
Nat. Biotechnol. 33:306-312(2015)
PubMed=25877200; DOI=10.1038/nature14397
Yu M., Selvaraj S.K., Liang-Chu M.M.Y., Aghajani S., Busse M., Yuan J., Lee G., Peale F.V., Klijn C., Bourgon R., Kaminker J.S., Neve R.M.
A resource for cell line authentication, annotation and quality control.
Nature 520:307-311(2015)
PubMed=26589293; DOI=10.1186/s13073-015-0240-5; PMCID=PMC4653878
Scholtalbers J., Boegel S., Bukur T., Byl M., Goerges S., Sorn P., Loewer M., Sahin U., Castle J.C.
TCLP: an online cancer cell line catalogue integrating HLA type, predicted neo-epitopes, virus and gene expression.
Genome Med. 7:118.1-118.7(2015)
PubMed=27397505; DOI=10.1016/j.cell.2016.06.017; PMCID=PMC4967469
Iorio F., Knijnenburg T.A., Vis D.J., Bignell G.R., Menden M.P., Schubert M., Aben N., Goncalves E., Barthorpe S., Lightfoot H., Cokelaer T., Greninger P., van Dyk E., Chang H., de Silva H., Heyn H., Deng X.-M., Egan R.K., Liu Q.-S., Miroo T., Mitropoulos X., Richardson L., Wang J.-H., Zhang T.-H., Moran S., Sayols S., Soleimani M., Tamborero D., Lopez-Bigas N., Ross-Macdonald P., Esteller M., Gray N.S., Haber D.A., Stratton M.R., Benes C.H., Wessels L.F.A., Saez-Rodriguez J., McDermott U., Garnett M.J.
A landscape of pharmacogenomic interactions in cancer.
Cell 166:740-754(2016)
PubMed=28196595; DOI=10.1016/j.ccell.2017.01.005; PMCID=PMC5501076
Li J., Zhao W., Akbani R., Liu W.-B., Ju Z.-L., Ling S.-Y., Vellano C.P., Roebuck P., Yu Q.-H., Eterovic A.K., Byers L.A., Davies M.A., Deng W.-L., Gopal Y.N.V., Chen G., von Euw E.M., Slamon D.J., Conklin D., Heymach J.V., Gazdar A.F., Minna J.D., Myers J.N., Lu Y.-L., Mills G.B., Liang H.
Characterization of human cancer cell lines by reverse-phase protein arrays.
Cancer Cell 31:225-239(2017)
PubMed=29444439; DOI=10.1016/j.celrep.2018.01.051; PMCID=PMC6343826
Yuan T.L., Amzallag A., Bagni R., Yi M., Afghani S., Burgan W., Fer N., Strathern L.A., Powell K., Smith B., Waters A.M., Drubin D.A., Thomson T., Liao R., Greninger P., Stein G.T., Murchie E., Cortez E., Egan R.K., Procter L., Bess M., Cheng K.T., Lee C.-S., Lee L.C., Fellmann C., Stephens R., Luo J., Lowe S.W., Benes C.H., McCormick F.
Differential effector engagement by oncogenic KRAS.
Cell Rep. 22:1889-1902(2018)
PubMed=29681454; DOI=10.1016/j.cell.2018.03.028; PMCID=PMC5935540
McMillan E.A., Ryu M.-J., Diep C.H., Mendiratta S., Clemenceau J.R., Vaden R.M., Kim J.-H., Motoyaji T., Covington K.R., Peyton M., Huffman K., Wu X.-F., Girard L., Sung Y., Chen P.-H., Mallipeddi P.L., Lee J.Y., Hanson J., Voruganti S., Yu Y., Park S., Sudderth J., DeSevo C., Muzny D.M., Doddapaneni H., Gazdar A.F., Gibbs R.A., Hwang T.H., Heymach J.V., Wistuba I.I., Coombes K.R., Williams N.S., Wheeler D.A., MacMillan J.B., DeBerardinis R.J., Roth M.G., Posner B.A., Minna J.D., Kim H.S., White M.A.
Chemistry-first approach for nomination of personalized treatment in lung cancer.
Cell 173:864-878.e29(2018)
PubMed=30894373; DOI=10.1158/0008-5472.CAN-18-2747; PMCID=PMC6445675
Dutil J., Chen Z.-H., Monteiro A.N.A., Teer J.K., Eschrich S.A.
An interactive resource to probe genetic diversity and estimated ancestry in cancer cell lines.
Cancer Res. 79:1263-1273(2019)
PubMed=31068700; DOI=10.1038/s41586-019-1186-3; PMCID=PMC6697103
Ghandi M., Huang F.W., Jane-Valbuena J., Kryukov G.V., Lo C.C., McDonald E.R. 3rd, Barretina J.G., Gelfand E.T., Bielski C.M., Li H.-X., Hu K., Andreev-Drakhlin A.Y., Kim J., Hess J.M., Haas B.J., Aguet F., Weir B.A., Rothberg M.V., Paolella B.R., Lawrence M.S., Akbani R., Lu Y.-L., Tiv H.L., Gokhale P.C., de Weck A., Mansour A.A., Oh C., Shih J., Hadi K., Rosen Y., Bistline J., Venkatesan K., Reddy A., Sonkin D., Liu M., Lehar J., Korn J.M., Porter D.A., Jones M.D., Golji J., Caponigro G., Taylor J.E., Dunning C.M., Creech A.L., Warren A.C., McFarland J.M., Zamanighomi M., Kauffmann A., Stransky N., Imielinski M., Maruvka Y.E., Cherniack A.D., Tsherniak A., Vazquez F., Jaffe J.D., Lane A.A., Weinstock D.M., Johannessen C.M., Morrissey M.P., Stegmeier F., Schlegel R., Hahn W.C., Getz G., Mills G.B., Boehm J.S., Golub T.R., Garraway L.A., Sellers W.R.
Next-generation characterization of the Cancer Cell Line Encyclopedia.
Nature 569:503-508(2019)
PubMed=31467290; DOI=10.1038/s41597-019-0166-7; PMCID=PMC6715692
Schoenherr R.M., Huang D.-Q., Voytovich U.J., Ivey R.G., Kennedy J.J., Saul R.G., Colantonio S., Roberts R.R., Knotts J.G., Kaczmarczyk J.A., Perry C., Hewitt S.M., Bocik W., Whiteley G.R., Hiltke T., Boja E.S., Rodriguez H., Whiteaker J.R., Paulovich A.G.
A dataset describing a suite of novel antibody reagents for the RAS signaling network.
Sci. Data 6:160-160(2019)"
孔培养体积缩小为 384 孔和 1536 孔形式的建议体积。由于接种体积和密度可能因细胞类型和下游应用而异,因此建议针对检测方案优化条件。 方法和材料 实验可以是贴壁生长癌细胞系的肿瘤干细胞,亦可是McCoy's 5a 培养基中培养的 T-29 人结肠癌细胞、F-12K (Kaighn's Mod.) 培养基中培养的 A549 人肺癌细胞,MCF7 人乳腺癌细胞。 另外,HTB-22™ 和 DU 145 人前列腺癌细胞均在杜氏改良 Eagle 培养基 (DMEM) 中培养。所有生长培养基均含有
生成树枝状传导气道网络(支气管、细支气管)和气体交换单元(肺泡)。 通过调整培养基的生长因子种类和含量,也可以在 22 天左右形成具有高度增殖能力的芽尖祖细胞类器官(bud tip progenitor organoid),这个结构具有体外多系分化潜能和体内移植潜能,因此芽尖祖细胞类器官是探索上皮命运决定的理想选择。而人肺类器官(human lung organoid, hLOs)的培养需要大约 50-85 天,适用于模拟人肺发育过程中的上皮-间充质转换。 这两种类器官都在再生医学、组织工程和药
一、实验材料NCI-H1299,购自上海晶莱生物技术有限公司。表 2.1.1 主要试剂试剂与耗材厂家(货号)细胞培养瓶FALCON 中国(353014)Penicillin/streptomycin solution(KGY002)0.25% Tripsin-EDTA(BK-E3076)PBS(BK330-2)胎牛血清GIBCO 美国(10270-106)1640 培养基Hyclone 美国(SH3080901)Annexin V-FITC/PI 凋亡试剂盒 二、实验仪器表 2.2.1 主要
 技术资料
技术资料暂无技术资料 索取技术资料

![NCI-H2087[H2087]人非小细胞肺腺癌传代细胞长期复苏|送STR图谱](https://img1.dxycdn.com/p/s14/2025/0213/020/4608046928343299881.jpg!wh200)

